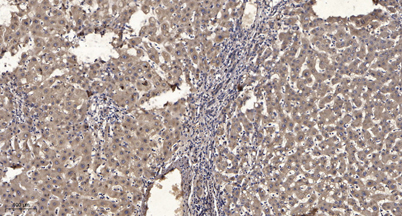

$148.00/50µL $248.00/100µL
| 50 µL | $148.00 |
| 100 µL | $248.00 |
| Product name: | SIAT9 rabbit pAb |
| Reactivity: | Human; Mouse;Rat |
| Source: | Rabbit |
| Dilutions: | WB 1:500-2000;IHC-p 1:50-300; ELISA 2000-20000 |
| Immunogen: | Synthesized peptide derived from human SIAT9 AA range: 157-207 |
| Storage: | -20°C/1 year |
| Clonality: | Polyclonal |
| Isotype: | IgG |
| Concentration: | 1 mg/ml |
| Molecular Weight: | 46kD |
| GeneID: | 8869 |
| Human Swiss-Prot No: | Q9UNP4 |
| Cellular localization: | Golgi apparatus membrane ; Single-pass type II membrane protein . |
| Background: | Ganglioside GM3 is known to participate in the induction of cell differentiation, modulation of cell proliferation, maintenance of fibroblast morphology, signal transduction, and integrin-mediated cell adhesion. The protein encoded by this gene is a type II membrane protein which catalyzes the formation of GM3 using lactosylceramide as the substrate. The encoded protein is a member of glycosyltransferase family 29 and may be localized to the Golgi apparatus. Mutation in this gene has been associated with Amish infantile epilepsy syndrome. Transcript variants encoding different isoforms have been found for this gene. [provided by RefSeq, Jul 2008], |